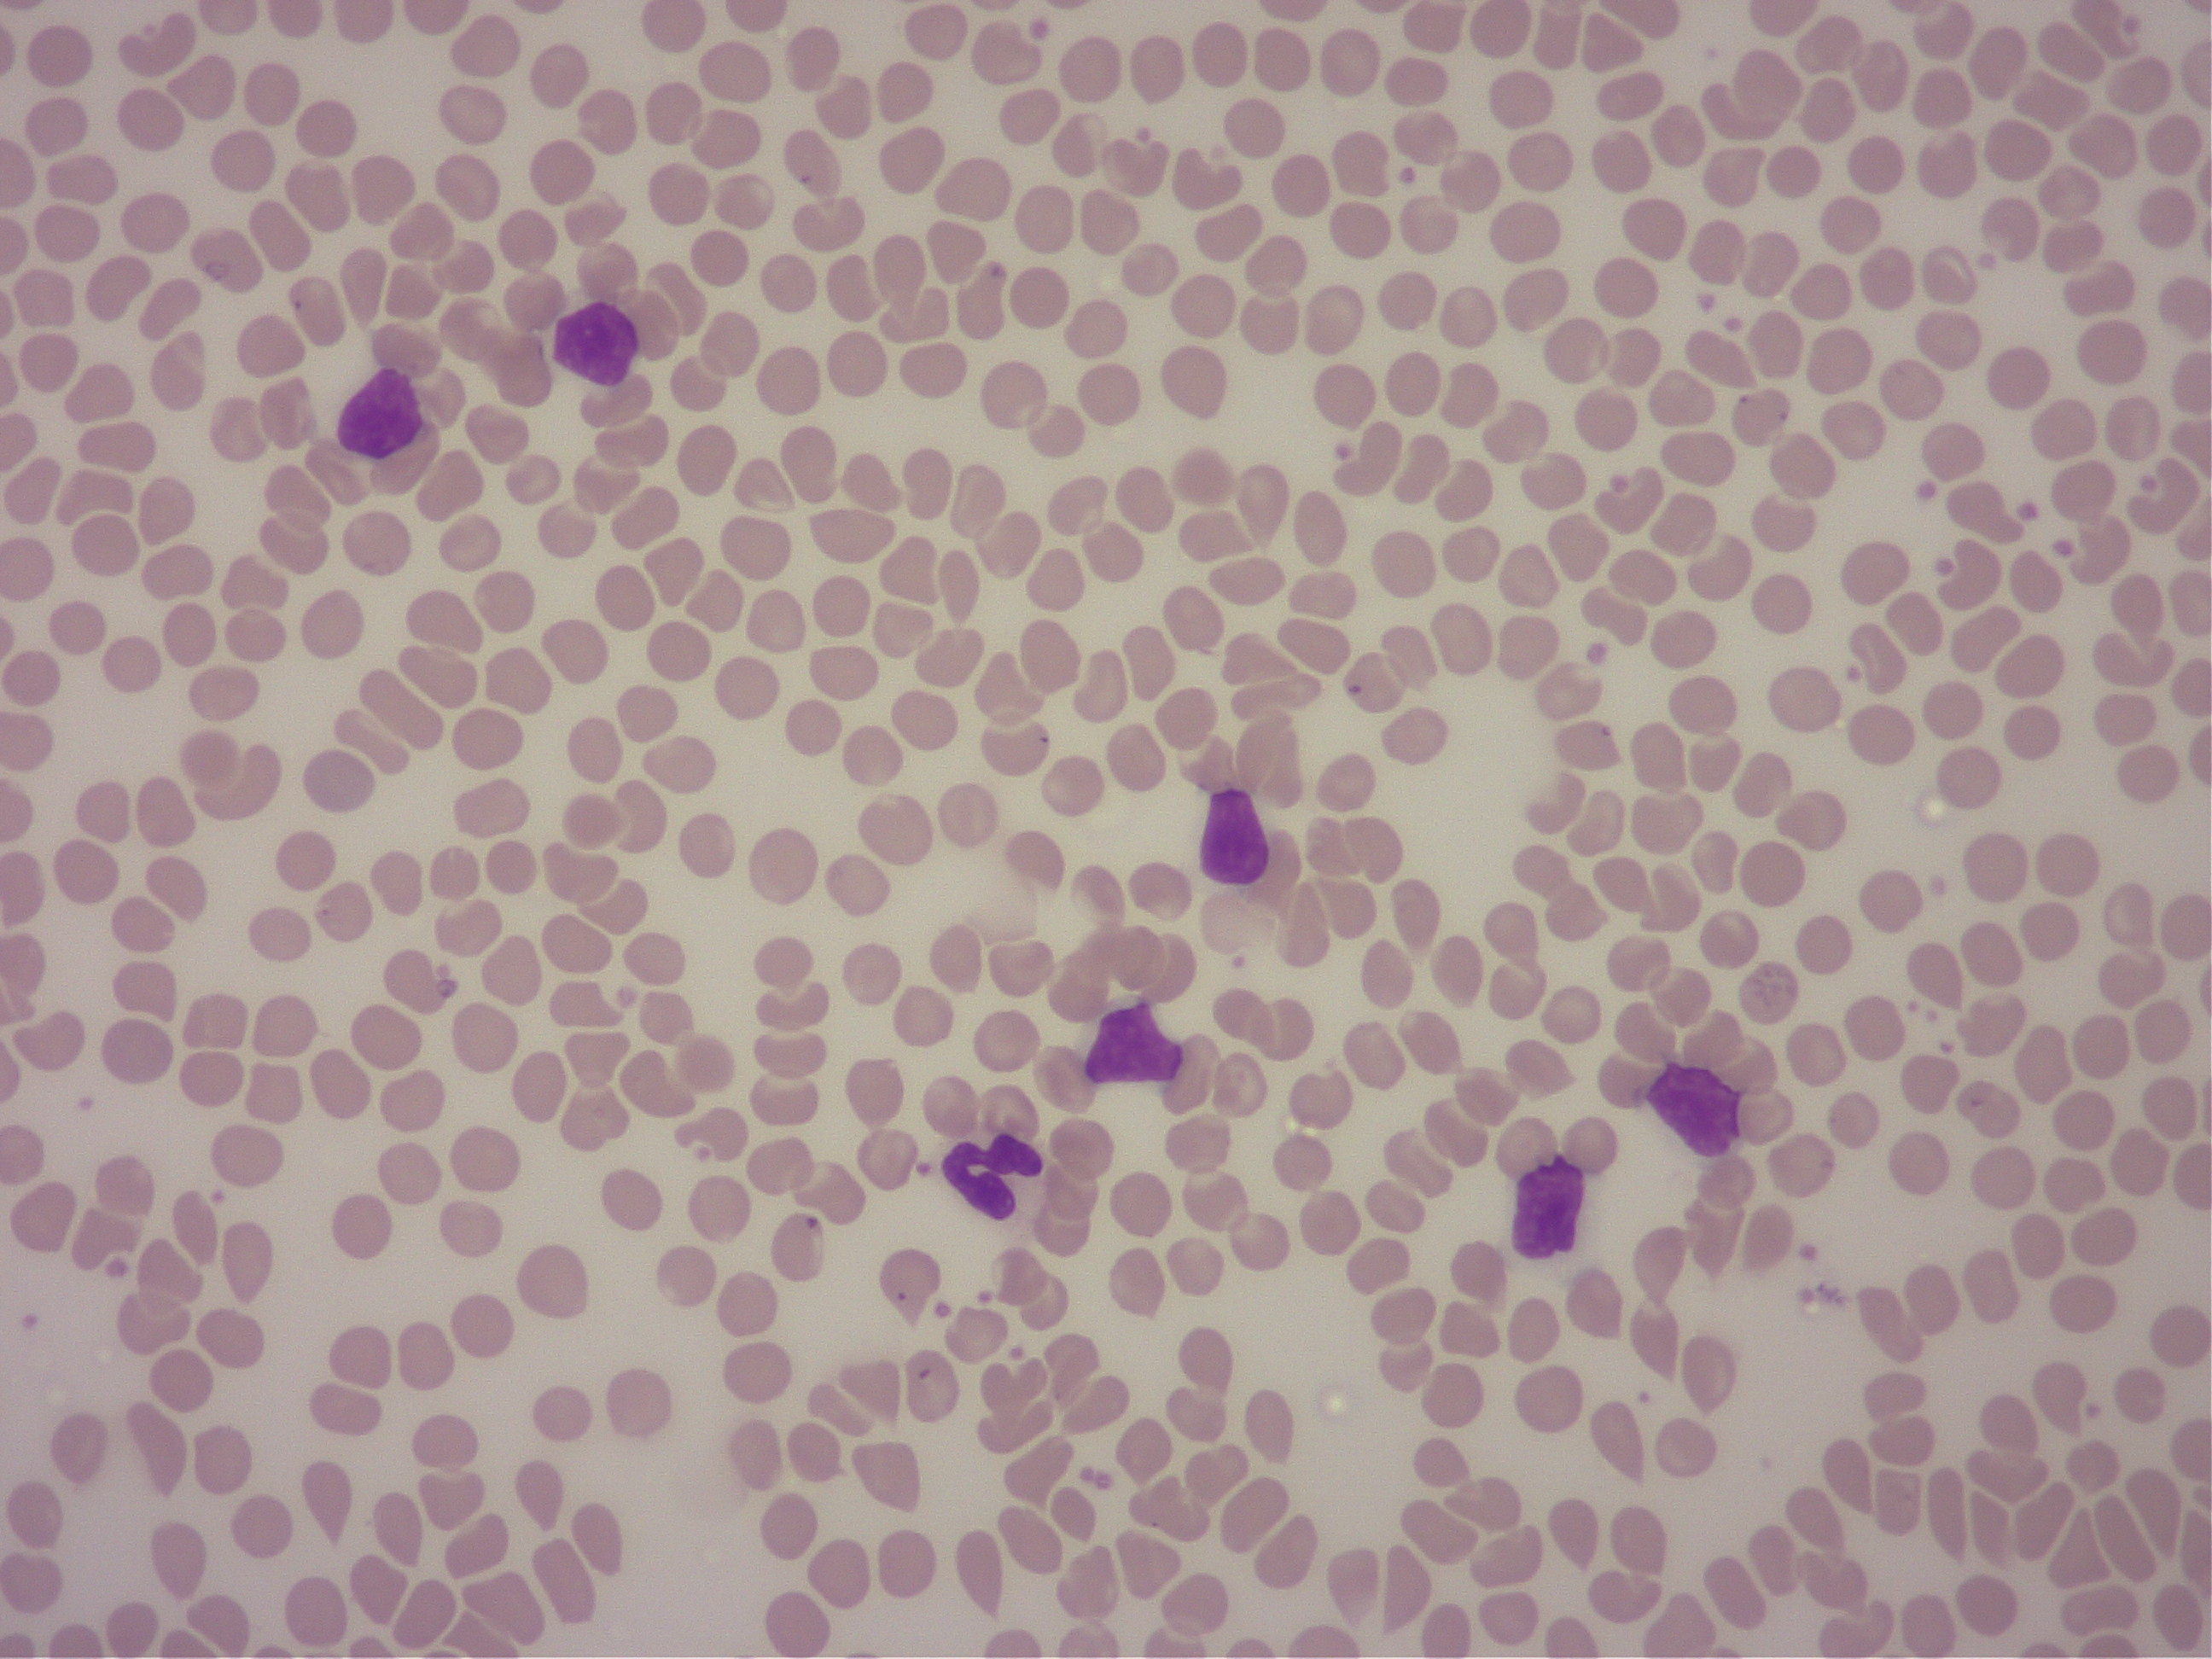
血液塗沫の顕微鏡検査画像

みなさん、こんにちは。院長の諏訪です。
例年よりとても早い梅雨入りで、
なんだか変な感じがしています。
先日の皆既月食も結局見れず。でした。
気候の変化は身体の変化にもつながると思っています。
小さな変化にいち早く気づいてあげてくださいね。

さて、本日は「犬の白血病」についてのお話です。
白血病は血液の細胞が「がん」になった病気です。
白血病には急性と慢性の2つのタイプがあります。
さらにそこから骨髄性白血病と
リンパ性白血病に分けられます。
それぞれ腫瘍になる細胞の起源が異なります。
さらに今回の話の中心となる慢性リンパ性白血病(CLL)は
T細胞性とB細胞性に分類されます。
人はB細胞性のタイプが多いですが、
犬ではT細胞性のタイプの報告が現時点では多いです。
今回は犬のB細胞性慢性リンパ性白血病(BCLL)についての
大規模な研究が2021年4月に
Journal of Veterinary Internal Medicineに
報告されましたので、
その内容(Abstract)をお話ししたいと思います。
背景
犬のB細胞性慢性リンパ性白血病(BCLL)は、
一般的に悪性度の低い疾患と考えられていますが、
これまでの研究の報告では
生存期間に大きな幅(ばらつき)があります。
目的
犬のBCLLがヒトの慢性リンパ性白血病と同様に
様々な臨床経過をとるという仮説を立てました。
そしてBCLLの犬における症状と転帰を評価し、
臨床的およびフローサイトメトリーなどの因子と
予後との関連性を評価することを目的としました。
症例
対象はフローサイトメトリーによって診断された
BCLLの犬121頭です。
BCLLのリスクが高いとされる小型犬(n=55)
変異していない免疫グロブリン遺伝子を
優先的にもつボクサー犬(n=33)
その他の犬種(n=33)
の3つの犬種グループに分けられました。
方法
BCLLを発症した犬の臨床症状、臨床病理学的データ、
身体検査所見、治療内容、生存期間を見直す
レトロスペクティブ(回顧的)な研究です。
細胞増殖についてはフローサイトメトリーにより
CD21+のB細胞にKi67が発現している細胞の割合で決定され、
121例中39例で測定されました。
また、臨床的評価および検査的評価と生存率との関連を評価しました。
結果
全症例の生存期間の中央値(MST)は
300日(1-1644日)でした。
ボクサーはボクサー以外の犬種に比べて
有意に生存期間が短く(MSTは178日)、
小型犬とその他のボクサー以外の犬種の間には
有意な生存期間の差は認められませんでした。
Ki67が高い症例(Ki67を発現しているB細胞が40%以上)は、
犬種を問わず、Ki67が40%未満の症例に比べて、
生存期間が有意に短かいものでした(MSTは173日)。
リンパ球数が多い(>60,000 /μL)症例や、
発症時に臨床症状がある症例は、
生存期間が有意に短いという結果でした。
まとめ
B細胞性慢性リンパ性白血病の臨床経過は多様であり、
ボクサー犬やKi67が高い症例は
より悪性度の高い疾患と考えられる結果でした。
以上が論文の要旨の内容になります。
海外はフローサイトメトリーを
一般的に用いることができるので
診断がとてもスムーズです。
日本ではまだまだ一般的な検査ではないため、
CLLの診断もやや異なります。
2011年の犬のCLLについての報告では、
BCLLのMSTは480日でした(Comazzi et al., 2011)。
今回の報告では300日というものでしたし、
ボクサー犬では180日と、
犬種や報告によっても差があることがわかります。
比較的稀な疾患であるため、
なかなかここまで大規模にまとめることが難しいですが、
今後のさらなる研究に期待されます。
緊急事態宣言も延長され、精神的にも疲労が出てきますね。
以前のような生活が戻ってくる日を信じ、
毎日をできるだけ元気に過ごしましょうね!!

6月も狂犬病集合注射の関係で
診察時間が変更となる日があります。
詳しくはこちらをご覧ください。
ご迷惑をおかけして申し訳ありませんが、
ご理解とご協力のほど、よろしくお願いいたします!
